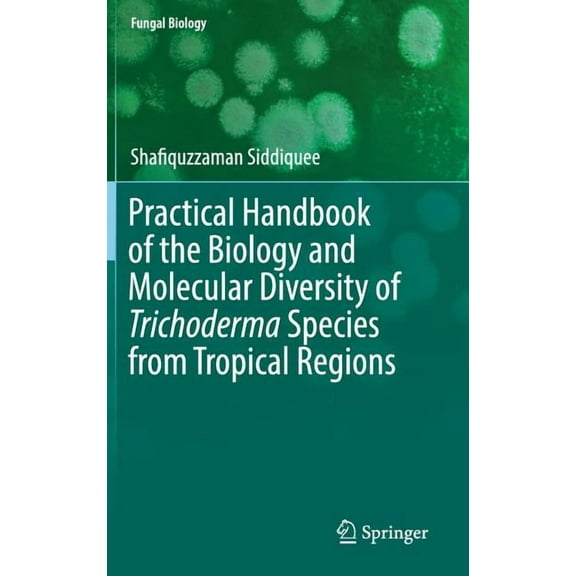
Fungal Biology Practical Handbook of the Biology and Molecular Diversity of Trichoderma Species from Tropical Regions, (Hardcover)

Hero image 0 of A Handbook of Tropical Soil Biology: Sampling and Characterization of Below-ground Biodiversity, (Paperback), 0 of 1
A Handbook of Tropical Soil Biology: Sampling and Characterization of Below-ground Biodiversity, (Paperback)
(No ratings yet)
Current price is USD$87.14
Price when purchased online
- Free shipping
- Free 30-day returns
How do you want your item?
Columbus, 43215
Arrives between Apr 10 - Apr 13
|Sold and shipped by Alibris Books
4.5644061375260465 stars out of 5, based on 10558 seller reviews(4.6)
Free 30-day returns
More seller options (1)
Starting from $95.41
About this item
Customer ratings & reviews
0 ratings|0 reviews
This item does not have any reviews yet
Related pages
- Connecticut Agricultural Experiment S
- Algae Taxonomy
- Tetragrammaton
- Agricultural Biologicals
- Taxonomic Nomenclature
- Ecological Disturbance
- General Ecosystem & Habitat Books
- Horticulture Life Science Books
- Mountain Ecosystem & Habitat Books
- Fisheries & Aquaculture Technology & Engineering Books
- Middle Atlantic
- River Ecosystem & Habitat Books